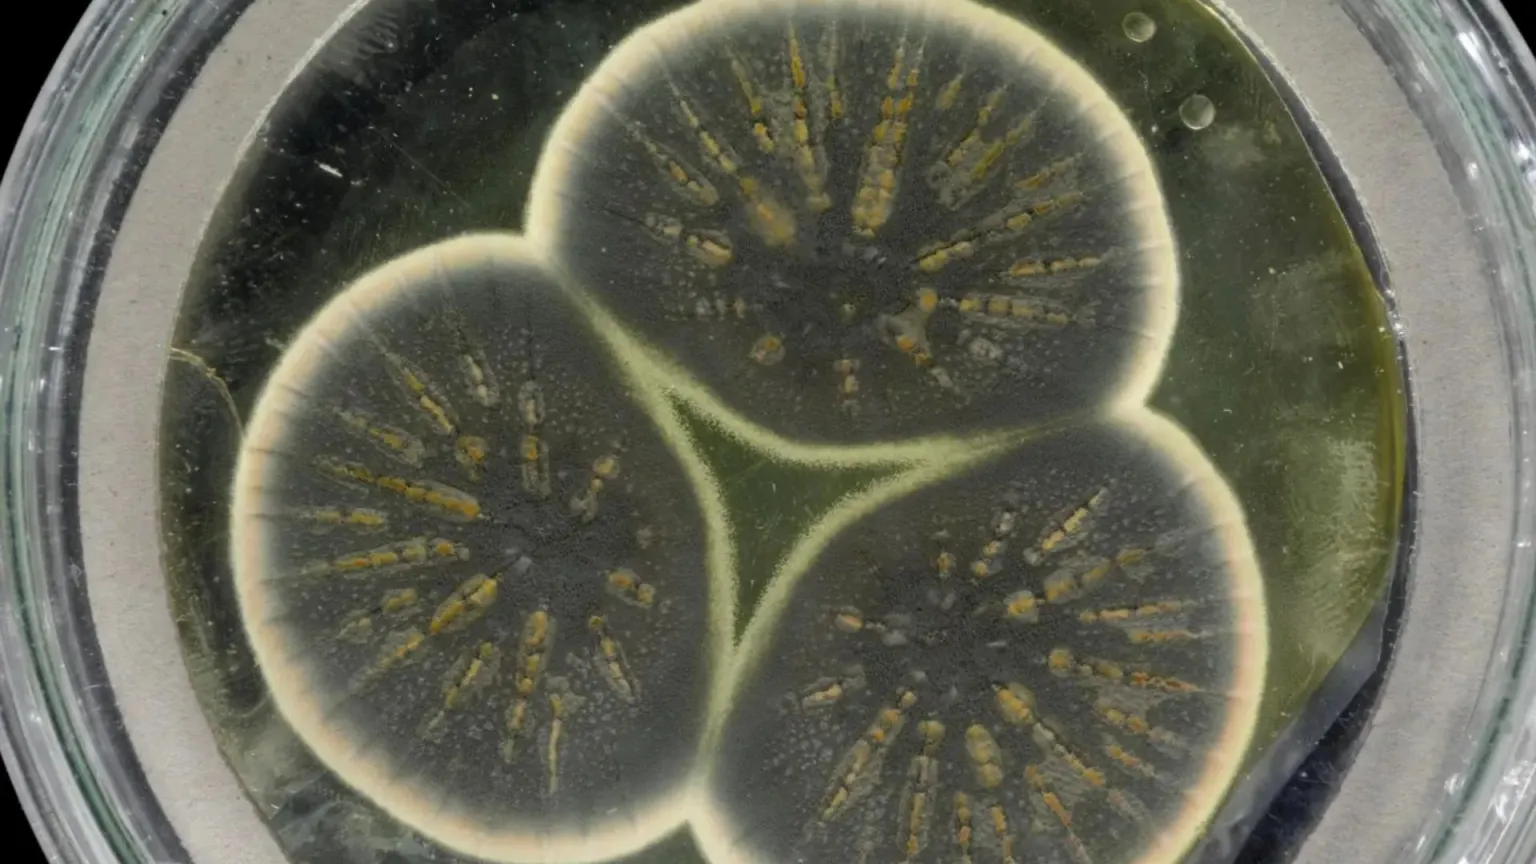
۱۰ کشف بزرگ علمی که جهان را برای همیشه تغییر داد

جدول تناوبی، نظریه فرگشت، الکتریسیته، واکسنها و موارد دیگر، مهمترین دستاوردهای علمی بشر هستند که چهره دنیا و دیدگاه انسان به جهان را برای همیشه تغییر دادند.
به گزارش ایسنا، اکتشافات جدید به طور مداوم دیدگاه ما را اصلاح میکنند و پیشرفتهای زیادی به طور مرتب گزارش میشود. یک پیشرفت علمی، چه انقلابی باشد و چه ظریف، هر یافته شکاف مهمی را پر میکند و علم و بشریت را به جلو میبرد.
دادهها نشان میدهند که در دو دهه گذشته رشد فوقالعادهای در پیشرفت علمی ایجاد شده است. به عنوان مثال بیش از ۴۰ میلیون مقاله تحقیقاتی بین سالهای ۲۰۰۳ تا ۲۰۲۲ منتشر شده است. علاوه بر این، تنها در سال ۲۰۲۲، تقریباً ۳.۳ میلیون مقاله در سراسر جهان منتشر شده است که به طور متوسط به معنی بیش از ۹ هزار مقاله در هر روز است.
اکنون میخواهیم ببینیم کدام اکتشافات آنقدر پیشگامانه بودند که به عنوان بزرگترین اکتشافات در تمام تاریخ مورد ستایش قرار بگیرند؟ بیایید نگاهی به ۱۰ مورد از آنها بیندازیم که اساساً درک ما از جهان را تغییر دادهاند.

جدول تناوبی عناصر
دیمیتری مندلیف(Dmitri Mendeleev) با معرفی جدول تناوبی خود در سال ۱۸۶۹ از هرج و مرج، نظم بیرون کشید. تا آن زمان، ۶۳ عنصر شیمیایی شناخته شده بدون یک سیستم منسجم پراکنده بودند که درک روابط و خواص آنها را برای دانشمندان دشوار میکرد.
مندلیف که مدرس دانشگاه سنتپترزبورگ روسیه بود، در آن زمان، «قانون تناوب» را فرموله کرد و عناصر را بر اساس وزن اتمی آنها مرتب کرد. جدول او نه تنها دانش موجود را روشنی بخشید، بلکه ویژگیهای سه عنصر کشف نشده دیگر شامل ژرمانیوم، گالیوم و اسکاندیم را نیز پیشبینی کرد.
سپس در سال ۱۹۱۳ بود که یک فیزیکدان انگلیسی به نام هنری موزلی(Henry Moseley)، جدول تناوبی را با سازماندهی عناصر بر اساس عدد اتمی آنها که برابر با تعداد پروتونهای هسته اتم آنهاست، اصلاح کرد.
امروزه جدول تناوبی با ۱۱۸ عنصر، سنگ بنای علم است که باعث پیشرفت در بسیاری از زمینهها و رشتهها میشود.

فرگشت(تکامل)
چارلز داروین(Charles Darwin)، طبیعتشناس انگلیسی پس از پنج هفته کاوش در حیات وحش در جزایر گالاپاگوس در سال ۱۸۳۵ دریافت که پرندگان آنجا، با وجود اینکه در جزایر جداگانه زندگی میکنند، یا از یک گونه هستند یا با مجموعهای از ویژگیهای منحصر به فرد بسیار نزدیک به هم هستند.
وی سالها بعد در سال ۱۸۵۹، پس از ساعتهای بیپایان از مقایسه و تجزیه و تحلیل نمونهها، کتاب «خاستگاه گونهها» را منتشر کرد و نظریه فرگشت(تکامل) را معرفی کرد. این نظریه میگوید که گونهها میتوانند در طول زمان تغییر کنند، گونههای جدید از گونههای قبلی موجود به وجود میآیند و همه آنها یک نیای مشترک دارند.
داروین همچنین پیشنهاد کرد که «فرگشت» از طریق انتخاب طبیعی اتفاق میافتد و تنها افراد شایسته زنده میمانند و تولید مثل میکنند و ویژگیهای مطلوب را به فرزندان خود منتقل میکنند.
در حالی که این کتاب، او را در مقابل کلیسای انگلستان در آن زمان قرار داد، اما از آن زمان به طور قابل توجهی نحوه درک ما از جهان طبیعی را تغییر داده است.
آنتیبیوتیکها
قبل از اینکه جناب الکساندر فلمینگ(Alexander Fleming) اولین آنتیبیوتیک مؤثر جهان به نام پنیسیلین(penicillin) را کشف کند، حتی چیزی به اندازه یک تاول میتوانست به دلیل عفونت باکتریایی کشنده باشد. اما به لطف هوش و تلاش این پزشک و میکروبیولوژیست اسکاتلندی، وی هنگام بازگشت از تعطیلات در سال ۱۹۲۸ به یکی از متحولکنندهترین یافتههای تاریخ دست یافت.
فلمینگ پس از بررسی یک ظرف پِتری مملو از باکتری استافیلوکوکوس که در آزمایشگاهش گذاشته بود، از مشاهده کپک در حال رشد در آن حیرتزده شد.
او خیلی زود متوجه شد که کپک مادهای را آزاد میکند که از رشد باکتریهای مجاور جلوگیری میکند و او را به انتشار یافتههای پیشگامانه خود در مقالهای در سال ۱۹۲۹ سوق داد.
یک دهه بعد، شیمیدانان دانشگاه آکسفورد اهمیت کار او را دریافتند و پنیسیلین را به یک داروی قابل استفاده تبدیل کردند.
با این حال، توجه به این نکته مهم است که در حالی که فلمینگ خواص آنتیبیوتیکی پنیسیلین را کشف کرد، تولید آن در مقیاس انبوه و استفاده گسترده از پنیسیلین تا دهه ۱۹۴۰ و به لطف محققانی مانند هاوارد فلوری(Howard Florey) و ارنست بوریس چین(Ernst Boris Chain) ممکن نشد.
دادهها نشان میدهد که از زمان کشف آنتیبیوتیکها، آنها میانگین عمر انسان را ۲۳ سال افزایش دادهاند.

واکسنها
ادوارد جنر(Edward Jenner)، پزشک و دانشمند انگلیسی در سال ۱۷۹۶، زمانی که متوجه شد دوشندگان شیر گاو که به آبله گاوی مبتلا شده بودند، در برابر آبله مقاوم هستند، مفهوم واکسن را مطرح کرد.
جنر مقداری از زخم آبله گاوی را از روی دست یک فرد شیردوش برداشت و آن را به بازوی پسری هشت ساله به نام جیمز فیپس(James Phipps) تلقیح(مایهکوبی) کرد. اگرچه فیپس یک واکنش موضعی را متحمل شد، اما در نهایت به طور کامل بهبود یافت.
وی موفقیت آزمایش خود را زمانی تایید کرد که چند ماه بعد، فیپس را با مقداری دیگر از زخم آبله تلقیح کرد و متوجه شد که این پسر به این بیماری مبتلا نشده است.
از آن زمان تاکنون، واکسنها نقش مهمی در نجات جان میلیونها نفر در سراسر جهان ایفا کردهاند. یک مطالعه اخیر از سازمان بهداشت جهانی(WHO) تخمین میزند که واکسنها در ۵۰ سال گذشته جان ۱۵۴ میلیون نفر را نجات دادهاند که تقریبا معادل ۶ نفر در هر دقیقه است.

نظریه مهبانگ
نظریه مهبانگ یا انفجار بزرگ(BIG BANG) میگوید که جهان در حدود ۱۳.۸ میلیارد سال پیش از یک حالت فوقالعاده متراکم و داغ پیش از انبساط سریع به کیهان وسیعی که امروز وجود دارد، پدید آمده است.
این نظریه در سال ۱۹۳۱ از جانب یک کشیش کاتولیک و فیزیکدان به نام ژرژ لومتر(Georges Lemaitre) پیشنهاد شد. او گفت که جهان در یک انفجار بزرگ از یک ذره به نام «اتم اولیه» ایجاد شده است و پس از این انفجار، جهان به اندازه کافی سرد شده و اجازه تشکیل ذرات و اتمهای زیر اتمی را داده است.
لومتر با بهکارگیری نظریه نسبیت عام آلبرت اینشتین در کیهانشناسی همچنین اظهار داشت که اجرام سیارهای دائماً از یکدیگر دور میشوند و این پدیده را با استفاده از مفهوم «جهان در حال انبساط هابل» توضیح میدهد.
اگرچه این نظریه هنوز مورد بحث است، اما با تشخیص تشعشعات و تابشهای پسزمینه مایکروویو کیهانی که خنکترین بقایای اولین نوری هستند که آزادانه در سراسر جهان حرکت میکنند، پشتیبانی میشود.

برق
الکتریسیته، نیرویی که دنیای مدرن ما را نیرو میدهد، اولین بار در حدود ۶۰۰ سال قبل از میلاد مسیح کشف شد، زمانی که تالس(Thales)، اندیشمند یونان باستان مشاهده کرد که مالش کهربا با خز یا پر باعث ایجاد جرقهای عجیب و غریب میشود.
با این حال، این پدیده برای نزدیک به ۲۰۰۰ سال به صورت یک راز باقی ماند تا اینکه سرانجام ویلیام گیلبرت(William Gilbert)، پزشک و دانشمند انگلیسی کتابی به نام دی مگنت(De Magnete) منتشر کرد و یافتههای خود را در مورد مغناطیس و الکتریسیته در سال ۱۶۰۰ ارائه کرد.
در سال ۱۷۵۲ بود که بنجامین فرانکلین(Benjamin Franklin)، یکی از بنیانگذاران آمریکا، آزمایش معروف بادبادکی خود را انجام داد. فرانکلین، کلیدی را به یک رشته بادبادک وصل کرد، آن را در هنگام طوفان به پرواز درآورد و ثابت کرد که رعد و برق، نوعی الکتریسیته است.
حدود یک قرن بعد، توماس ادیسون(Thomas Edison) اولین لامپ رشتهای قابل دوام تجاری را توسعه داد. این در حالی بود که پیش از آن نیکولا تسلا(Nikola Tesla)، مهندس صربستانی-آمریکایی موفق به تولید، انتقال و استفاده از جریان متناوب(AC) شده بود که امکان انتقال الکتریسیته در فواصل بسیار دورتر را فراهم میکرد.

جاذبه
جناب اسحاق نیوتن(Isaac Newton)، ریاضیدان و فیزیکدان انگلیسی، یک پیشگام واقعی در اکتشافات مختلف بود، اما شاید پیشگامانهترین کشف او، کشف یک نیروی رازآلود بود که ما آن را گرانش یا جاذبه مینامیم. نیوتن جاذبه را در سال ۱۶۶۴ کشف کرد.
افسانهها حاکی از آن است که افتادن یک سیب از درختی در یک باغ، نیوتن را به درک این نیرو و اینکه چرا جهان همه چیز را در مدار نگه میدارد، سوق داد و او را به تدوین قوانین حرکت و گرانش جهانی ترغیب کرد.
در حالی که واقعا مشخص نیست که آیا واقعا حادثه سقوط سیب رخ داده است یا خیر، نیوتن کشف کرد که گرانش، نیرویی است که اجسام را به سوی هم میکشد و توضیح میدهد که اشیاء چرا سقوط میکنند و سیارات چگونه به دور خورشید میچرخند.
یافتههای او توسط آلبرت اینشتین که یک فیزیکدان نظری بود، در سال ۱۹۱۵ پشتیبانی شد که نظریه نسبیت عام او گرانش را به عنوان انحنای فضا-زمان که در نتیجه حضور جرم و انرژی ایجاد شده است، بازتعریف کرد.

دیانای
«اسید دئوکسیریبونوکلئیک» که به طور گسترده به عنوان دیانای(DNA) شناخته می شود، یک ماده ارثی است که تقریباً در تمام موجودات زنده یافت میشود. چهار پایه شیمیایی آن شامل آدِنین(A)، گوانین(G)، سیتوزین(C) و تیمین(T)، اطلاعات ژنتیکی را به عنوان یک کد منحصر به فرد ذخیره میکنند که همه چیز را از ویژگیهای فیزیکی تا عملکردهای بیولوژیکی ضروری هدایت میکند.
اگرچه جیمز واتسون(James Watson) و فرانسیس کریک(Francis Crick) برای کشف ساختار مارپیچ سهبعدی دیانای در سال ۱۹۶۲ جایزه نوبل دریافت کردند، اما این مولکول برای اولین بار توسط یک پزشک سوئیسی به نام فردریش میشر(Friedrich Miescher) شناسایی شد که با موفقیت اسید نوکلئیک را در سال ۱۸۶۹ جدا کرد.
کشف ساختار دیانای در سال ۱۹۵۳ نیز با کار پیشگامانه پراش پرتو ایکس دکتر روزالیند فرانکلین(Rosalind Franklin) در کالج دانشگاهی لندن امکانپذیر شد. عکس نمادین او موسوم به «عکس ۵۱» به وضوح، مارپیچ دوگانه اسید دئوکسیریبونوکلئیک را نشان داد و مدل مارپیچ سهگانه قبلی پیشنهاد شده توسط واتسون و کریک را به چالش کشید.

نظریه میکروب
این نظریه نشان میدهد که بیماریهای خاص توسط ریزموجودات یا میکروارگانیسمهایی به نام پاتوژنها یا «میکروبها» ایجاد میشوند که آنقدر ریز هستند که فقط زیر میکروسکوپ قابل مشاهده هستند.
این نظریه امروزه به طور گسترده پذیرفته شده است و نشان میدهد که این میکروارگانیسمها، بهویژه باکتریها و ویروسها به بدن انسان حمله میکنند و تکثیر میشوند و رشد و تولید مثل آنها موجب بیماری میشود.
نظریه میکروب در اواسط قرن نوزدهم شکل گرفت، زمانی که شیمیدان و میکروبیولوژیست فرانسوی لوئی پاستور(Louis Pasteur) نشان داد که میکروبهای مسئول فاسد شدن شیر را میتوان از طریق گرما از بین برد. این فرآیند انقلابی اکنون به عنوان «پاستوریزه کردن» شناخته میشود.
این نظریه در دهه ۱۸۸۰ زمانی که رابرت کخ(Robert Koch)، پزشک آلمانی، ارگانیسمهای خاص مسبب بیماریهای سل و وبا را شناسایی کرد، مورد حمایت بیشتری قرار گرفت.

کریسپر(CRISPR)
فناوری پیشگامانه ویرایش ژن که مخفف عبارت Clustered Regularly Interspaced Short Palindromic Repeats به معنی «تناوبهای کوتاه پالیندروم فاصلهدار منظم خوشهای» است، امکان اصلاح دقیق دیانای ارگانیسم را با مکانیابی توالیهای خاص در یک سلول فراهم میکند.
دانشمندان با استفاده از یک آرانای(RNA) راهنما برای هدایت آنزیم کس۹(Cas۹) به دیانای هدف میتوانند توالی انتخاب شده را تغییر دهند یا آن را با یک توالی دیگر جایگزین کنند. این فرآیند به آنها اجازه میدهد تا مواد ژنتیکی را برش دهند، توالیهای جدید اضافه کنند، موارد ناخواسته را حذف کنند یا ژنهای موجود را با دقتی استثنایی تغییر دهند.
این فناوری از یک محرک ژنی استفاده میکند تا اطمینان حاصل کند که ژن اصلاح شده توسط نسل بعدی به ارث میرسد.
در سال ۲۰۲۰ بود که امانوئل شارپنتیه(Emmanuelle Charpentier)، میکروبیولوژیست، ژنتیکشناس و زیستشیمیدان فرانسوی و جنیفر دودنا(Jennifer Doudna)، زیستشیمیدان آمریکایی به دلیل توسعه این تکنیک ویرایش ژن، جایزه نوبل شیمی را دریافت کردند.
انتهای پیام